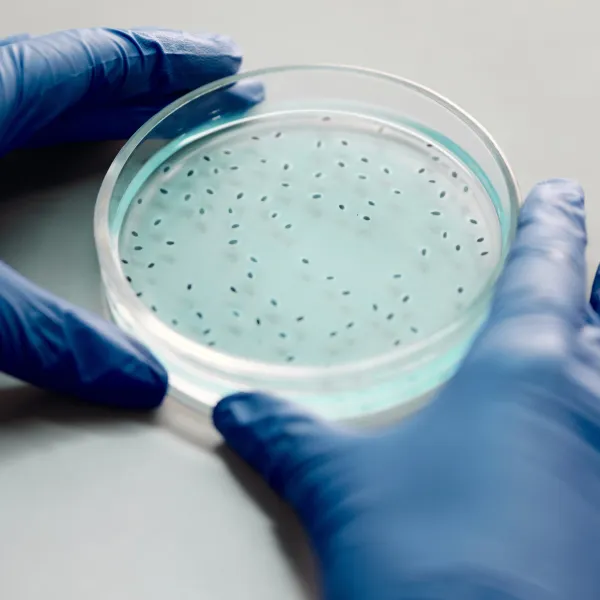
Culture des cellules - Air Liquide

Des solutions sûres et fiables pour les gaz de haute pureté

Un niveau de fiabilité maximal
Air Liquide est leader dans la fourniture de gaz et de solutions conformes aux exigences de fabrication des acteurs des secteurs pharmaceutique et biotechnologique. Soucieuse de la sécurité du patient, cette industrie est très strictement réglementée : les niveaux de qualité y sont très élevés, la traçabilité obligatoire et le contrôle comme la maîtrise des procédés de fabrication impératifs.
Présent sur l'ensemble de la chaîne de valeur de l'industrie pharmaceutique
Grâce à notre connaissance des réglementations internationales, nous répondons à leurs exigences en produisant des gaz de grande pureté, fiables, selon des méthodes d'approvisionnement sécurisées. Notre expertise reconnue dans les applications de régulation de température et de mélange gaz-liquide nous permet d'intervenir également sur l'ensemble de la chaîne de valeur de l'industrie pharmaceutique : les laboratoires de Recherche & Développement, les producteurs de principes actifs, les laboratoires pharmaceutiques, etc.
Les laboratoires d'analyse réalisent régulièrement des contrôles de la qualité des matières premières, ainsi que des produits intermédiaires et finaux, afin de connaître les concentrations des divers composants ou de détecter la présence d'impuretés.

Des solutions fiables pour un marché ultra-concurrentiel
L’exhaustivité de nos services contribue à forger notre réputation de fiabilité auprès des grands acteurs internationaux de l’industrie pharmaceutique et biotechnologique. Notre gamme de gaz de qualité pharmaceutique PHARGALIS™ répond à la fois aux besoins de performance et de respect des normes réglementaires.
Conçus pour la fabrication de principes pharmaceutiques actifs (PPA) et de médicaments, nos gaz sont traçables et livrés avec leurs certificats d'analyse et de conformité.
Les produits PHARGALIS™ ont été développés dans le respect des Bonnes Pratiques de Fabrication (BPF) et sont conformes aux trois principales pharmacopées (USP-NF, Ph. Eur. et JP). Ils sont employés pour l'inertage à tous les stades de la production. Nos solutions permettent notamment de préserver la qualité des principes actifs et des médicaments, afin de prévenir tout risque d’oxydation ou de contamination microbiologique des produits de nos clients.
Outre nos gaz PHARGALIS™, nous proposons des solutions dédiées pour des applications connexes : refroidissement des réacteurs, culture cellulaire, logistique de la chaîne du froid et conservation cryogénique.

Fabrication d'ingrédients pharmaceutiques actifs
Vous travaillez dans le secteur de la biofabrication de grosses molécules biologiques, telles que des protéines à usage thérapeutique ? Vous synthétisez des médicaments à petites molécules ? Air Liquide est capable de répondre à vos besoins. Nous proposons par exemple des systèmes de régulation de la température, d'inertage et de cryoconservation, et pouvons même vous aider à mieux respecter les normes environnementales.
En tant qu'intervenant dans la chaîne d'approvisionnement pharmaceutique, Air Liquide comprend parfaitement les attentes et les besoins que les sociétés pharmaceutiques et biotechnologiques exigent de leurs fournisseurs. C'est pourquoi, Air Liquide travaille sans relâche pour assurer la qualité, la sécurité et l'uniformité des produits à travers ses offres et solutions gaz Phargalis.

Formulation, conditionnement et distribution
Les industries pharmaceutiques et biotechnologiques continuent d'innover et de développer des molécules de plus en plus complexes et précieuses, dans le but d'améliorer la qualité de vie des patients. Il est donc essentiel de préserver l'intégrité du produit jusqu'à son administration afin d'assurer l'effet thérapeutique désiré du médicament.
Que vous souhaitiez gérer l'exposition en oxygène des produits sensibles, optimiser la formulation de médicaments ou conserver la température de la chaîne du froid pour vos échantillons cliniques et biologiques, Air Liquide possède les solutions qu'il vous faut pour améliorer la stabilité des produits. Nos ingénieurs des procédés sont là pour partager leur expertise avec vous. Ils vous aideront à concevoir des installations gaz et à choisir les méthodes d'approvisionnement qui correspondent à votre activité.

Recherche et contrôle qualité
Avec Air Liquide, les clients qui effectuent des travaux de recherche, des essais et des prises de mesure peuvent compter sur un niveau d'expertise équivalent au leur. Ils attendent de nos équipes qu’elles anticipent leurs besoins et développent de manière proactive des solutions intelligentes adaptées à leurs recherches.
C’est pourquoi nous proposons une large gamme de gaz d'analyse de qualité, parmi lesquels figurent des gaz purs et des mélanges, ainsi que les équipements de mise en œuvre et les services associés. ALPHAGAZ™, notre gamme mondiale de gaz de spécialité (purs et mélanges) destinés aux applications d'analyse.
Gaz et équipements
Avez-vous des questions sur les solutions pharmaceutiques et biotechnologies ? Veuillez remplir notre formulaire de contact.
Nos experts vous répondront dans les 24 heures.